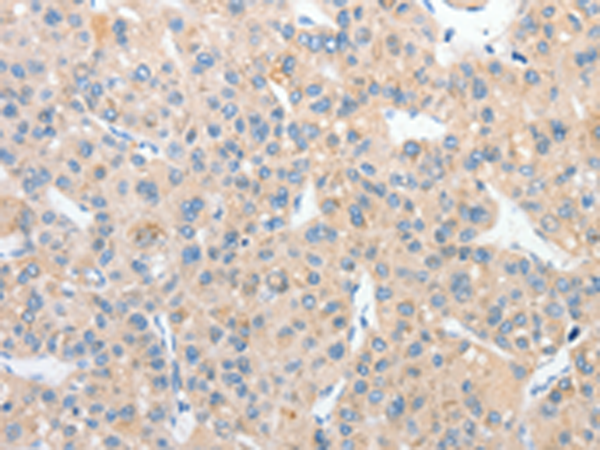
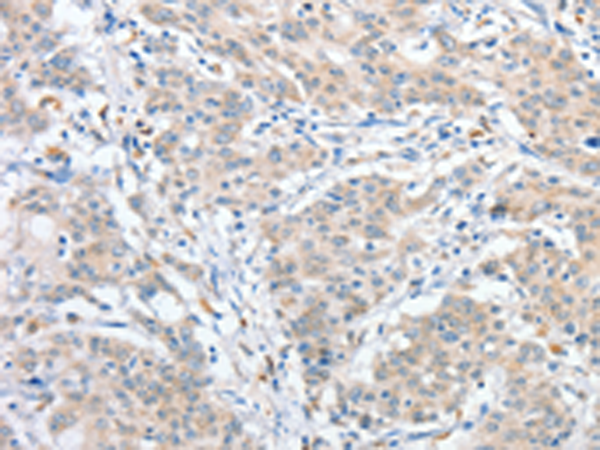

-
分类: 科研抗体货号: P07936别名: OST1; RBPH1应用: WB,IHC反应种属: Human, Mouse, Rat
-
分类: 科研抗体货号: P07915别名: APG4D; AUTL4; APG4-D应用: IHC反应种属: Human, Mouse
-
分类: 科研抗体货号: P07920别名: BCLG应用: IHC反应种属: Human
-
分类: 科研抗体货号: P07935别名: STAM1; STAM-1应用: IHC反应种属: Human, Mouse
-
分类: 科研抗体货号: P07913别名: ARTC5应用: IHC反应种属: Human, Mouse
-
分类: 科研抗体货号: P07919别名: AOS1; SUA1; UBLE1A; HSPC140应用: WB,IHC反应种属: Human, Mouse, Rat
-
分类: 科研抗体货号: P07934别名: DA41; DSK2; UBQN; XDRP1; PLIC-1应用: WB,IHC反应种属: Human, Mouse, Rat
-
分类: 科研抗体货号: P07912别名: ARTC3应用: IHC反应种属: Human
-
分类: 科研抗体货号: P07950别名: HIP4应用: WB,IHC反应种属: Human, Mouse, Rat
-
分类: 科研抗体货号: P07931别名: UCH37; CGI-70; INO80R; UCH-L5应用: IHC反应种属: Human, Mouse

鄂公网安备42018502007531号
鄂公网安备42018502007531号

